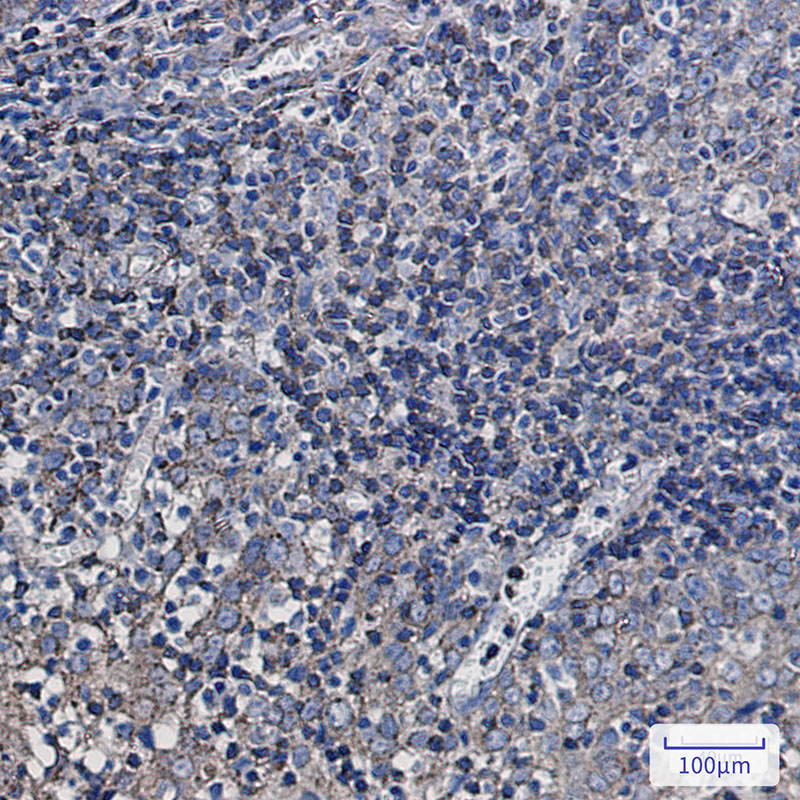
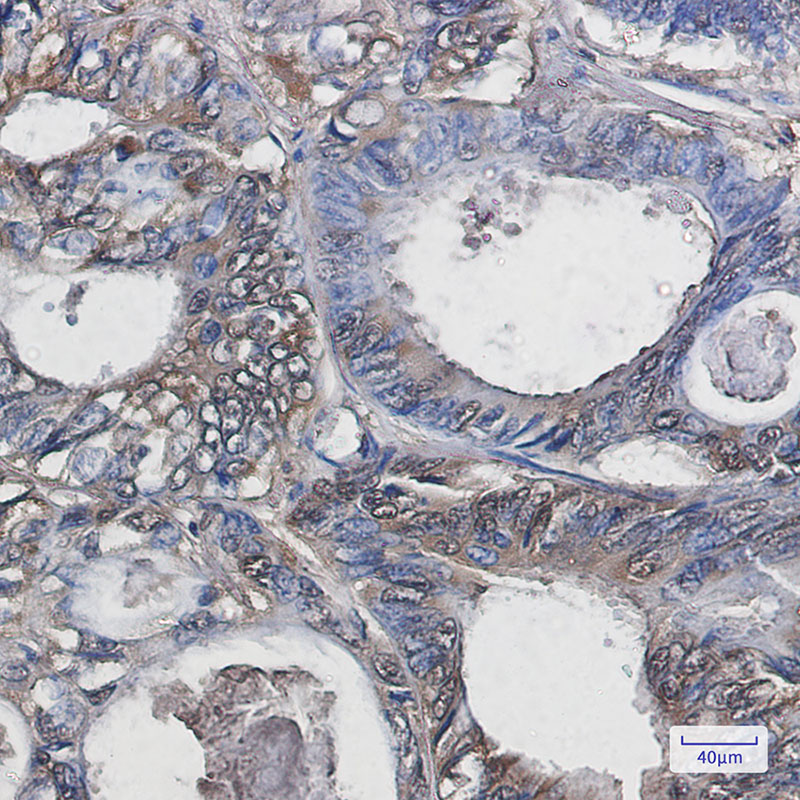

-
分类: 科研抗体货号: P22033别名: SS3R; SS3-R; SS-3-R; SSR-28应用: WB反应种属: Human
-
分类: 科研抗体货号: P22050别名: Hop; P60; STI1; STI1L; STIP1; Stress induced phosphoprotein 1应用: WB,IP,IHC反应种属: Human,Mouse,Rat
-
分类: 科研抗体货号: P22068别名: Pantophysin; SYPL1应用: WB,IHC反应种属: Human
-
分类: 科研抗体货号: P22061别名: SP-D; Sfpd; Sftp4; AI573415应用: WB,IHC反应种属: Rat
-
分类: 科研抗体货号: P22049别名: STAU; PPP1R150应用: WB,IHC反应种属: Human,Mouse,Rat
-
分类: 科研抗体货号: P22067别名: Alpha 1 syntrophin; LQT12; SNT1; Snta1; Syntrophin 1; TACIP1应用: WB,IHC,IF反应种属: Human
-
分类: 科研抗体货号: P22060别名: SOD1; Superoxide dismutase [Cu-Zn]; Superoxide dismutase 1; hSod1应用: WB,IHC反应种属: Human,Mouse,Rat
-
分类: 科研抗体货号: P22047别名: MGF; STAT5应用: WB,IP,IF反应种属: Human,Mouse,Rat
-
分类: 科研抗体货号: P22066别名: p35 2; PLACENTAL; Stx4; STX4A; Syntaxin 4; syntaxin 4A应用: WB反应种属: Human,Mouse,Rat
-
分类: 科研抗体货号: P22058别名: Sun1; UNC84A应用: WB,IHC,IF反应种属: Human

鄂公网安备42018502007531号
鄂公网安备42018502007531号

